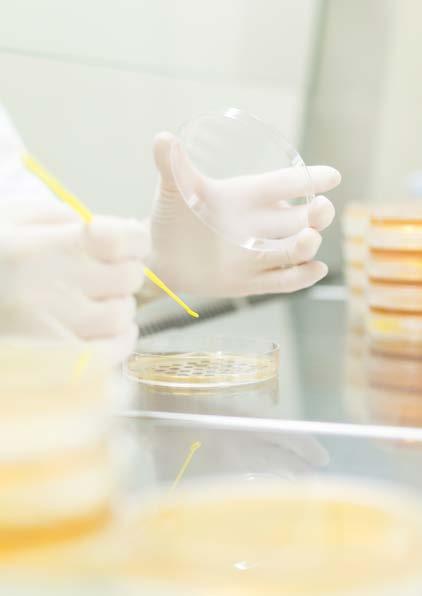

4
GIẤC MƠ ẤP Ủ

Mến chào Người Bạn của chúng tôi, Dù bạn là ai đi nữa, chúng tôi cũng xin mở đầu câu chuyện sắp kể bằng lời Cảm Ơn vì đã lật mở trang sách này, như mở ra một cơ duyên để chúng tôi được chia sẻ với bạn về chuyện của Bếp Nàng Cò.
5
Là những doanh nhân và cũng là những người cha người mẹ, thế nên hình ảnh về những bữa ăn cần dinh dưỡng, đủ cảm xúc cứ day dẵng và để lại trong chúng tôi một nỗi niềm to lớn.
Qua những câu chuyện cùng bạn bè, anh chị em nhân viên có con cháu đang ở lứa tuổi cấp I, chúng tôi lại bắt gặp những cái cau mày, những lời chia sẻ đầy tâm tư lẫn sự mong đợi về chất lượng, khẩu vị làm sao để phù hợp cho trẻ.
Thỉnh thoảng, chúng tôi lại lặng người khi đọc những bài báo đưa tin về một vụ ngộ độc thực phẩm ở các em học sinh. Nhẹ thì nhập viện rồi các em lại hồi phục, nặng thì... Một vài con số đưa ra làm chúng tôi thấy nhói nơi lồng ngực. Trong những câu chuyện như thế, các em không thể chủ động được việc lựa chọn nạp vào người những loại thức ăn gì, những chất dinh dưỡng nào. Nỗi trăn trở cứ thế mạnh mẽ hơn.
Trăn trở làm thế nào để giúp các con yêu thích mỗi bữa ăn, vui vẻ, hạnh phúc khi ngồi trước khay cơm...
Trăn trở làm thế nào để tạo ra được những phần ăn đảm bảo an toàn vệ sinh thực phẩm.
Trăn trở trước nỗi khổ niềm đau và tình yêu thương vô bờ bến của các bậc làm cha, làm mẹ sẵn sàng làm mọi điều với mong muốn các con luôn được phát triển toàn diện cả về thể chất lẫn tinh thần.
Tất cả nhưng trăn trở ấy lớn dần, lớn dần và chuyển thành một thôi thúc mạnh mẽ:
CHÚNG TÔI PHẢI LÀM GÌ ĐÓ!!!
Và thế là... Bếp Nàng Cò ra đời.


6
Từ những nỗi niềm, mà sâu xa hơn là tình yêu thương dành cho trẻ nhỏ, sự đồng cảm, sẻ chia với các bậc phụ huynh, ước muốn đồng hành, chung sức gánh vác trách nhiệm với nhà trường, xã hội trong việc quan tâm, yêu thương, chăm sóc các con, Bếp Nàng Cò mang trong mình một hoài bão được trao hương vị yêu thương đến các em nhỏ qua những bữa ăn: An toàn - Dinh dưỡng - Ngon miệng - Đẹp mắt - Đầy ắp niềm vui.

lẫn đời sống cảm xúc của các con trên chặng đường vươn tới tương lai.
Tập thể Bếp Nàng Cò.


7

8
NỘI DUNG

Phần 1: Hiện thực hóa ước mơ
Phần 2: Tình cảm trong từng bữa ăn
Phần 3: Niềm vui trên bàn ăn Lời cảm ơn 10 20 34 60 9



10
PHẦN 1: HIỆN THỰC HÓA ƯỚC MƠ
“
Từ thôi thúc “phải làm điều gì đó” cho các con trong từng bữa ăn ở trường, chúng tôi quyết tâm biến ước mơ thành sự thật. Mặc cho những thử thách ban đầu, Bếp Nàng Cò cứ từng bước, từng bước bồi đắp và không ngừng tìm kiếm những cánh tay nối dài để hoàn thành thật tốt sứ mệnh của mình.


11

12

Có một loại dinh dưỡng mang tên “
NIỀM VUI
13
BẠN ĐỒNG HÀNH ƠI,


Từ khi khởi sự dự án này, chúng tôi luôn có một niềm tin mãnh liệt rằng ngoài kia chắc chắn cũng có những người có cùng niềm mong ước với mình. Chúng tôi tin, hạt mầm điều tốt một khi đã được gieo xuống thì cho dù khó khăn thế nào rồi cũng tìm được nguồn dưỡng chất và cách tưới tiêu phù hợp để đâm chồi nảy lộc.
Vậy là, trên hành trình gieo hạt ấy, chúng tôi đã liên tục tìm kiếm những cộng sự, đối tác để có thể cùng nhau chăm sóc cho hạt nảy mầm càng sớm càng tốt. Từ năm 2019 đến nay, thành thật là chúng tôi cũng đã không ít lần vấp ngã, cũng đã nếm trãi nhiều ngậm ngùi khi kết quả trái ngược với mục tiêu, cũng đã chịu nhiều tổn thất về thể chất, tinh thần và cả tài chính. Hành trình ấy đã có những người đến rồi đi, chúng tôi có những cái bắt tay ngắn ngủi khi không cùng quan điểm thực thi.
14
Tuy vậy, với niềm tin về một mầm tốt chắc chắn sẽ có ngày vươn mình thành cây và trĩu quả, chúng tôi tiếp tục mang hạt mầm của mình tìm kiếm những người bạn đồng hành có chung niềm tin yêu và tầm nhìn để cùng nhau vun xới, chăm bón. Giờ đây, bằng tất cả sự nỗ lực tìm kiếm chúng tôi đã có được những đối tác, những người đồng đội tin cậy. Cùng nhau chúng tôi không ngừng mày mò tìm hiểu, hoàn thiện kiến thức làm thế nào để có thể cung cấp các suất ăn phù hợp cho trẻ.


15
NHỮNG CON NGƯỜI
YÊU NGHỀ, MẾN TRẺ
Chúng tôi tự hào khi bên trong Bếp Nàng Cò là một đội ngũ giàu tâm huyết, đủ yêu thương và đầy trách nhiệm trong việc sản xuất, cung ứng các suất ăn mỗi ngày cho các con. Và đội ngũ ấy đang ngày càng
hoàn thiện về mặt tay nghề theo các tiêu chuẩn nghiêm ngặt được đề ra.
Chúng tôi không ngừng nhắc nhỡ nhau về thôi thúc ban đầu khi
thành lập Bếp Nàng Cò, đó như nguồn sức mạnh và chất keo kết dính chúng tôi đồng lòng, đồng sức vun vén cho mầm non điều tốt về những bữa ăn giàu dinh dưỡng và niềm vui. Tất cả nhân viên của
Bếp Nàng Cò luôn ý thức cao trong
việc học tập và tuân thủ những quy




16

Ở Bếp Nàng Cò, chúng
tôi luôn tự hỏi: “Mình có thể làm tốt hơn công việc này bằng cách

khác không? Làm như thế này thì có đạt tiêu chuẩn của khách hàng, đối tác chưa? Và đặc biệt là phần ăn với định lượng, màu sắc, mùi vị thế này các con em có thích không, có hào hứng khi ăn chưa?…”
Không ngừng đặt câu hỏi và không ngừng tìm kiếm câu trả lời, là một trong những cách chúng tôi đang ngày ngày hoàn thiện

Không chỉ là sức mạnh nội tại, chúng tôi còn được tiếp sức từ nguồn lực mạnh mẽ bên ngoài. Đó là những khách hàng, đối tác tuyệt vời khi hợp tác, là những cánh tay nối dài mang bữa ăn dinh dưỡng đến các con. Ấy chính là các thầy cô hiệu trưởng, các vị lãnh đạo của Phòng Giáo dục, Sở Giáo dục. Chúng tôi vô cùng biết ơn khi đã tìm được những “người bạn đồng hành” yêu nghề mến trẻ, có thể hòa cùng cảm xúc và đồng ý lên chung chuyến thuyền. Ở đó là sự trao gửi niềm tin, quan tâm, chia sẻ, góp ý thậm chí nhắc nhở để chúng tôi ngày càng hoàn thiện mình hơn.

17

“NHÀ SẠCH THÌ MÁT, BÁT SẠCH NGON CƠM”
Có thể xem mô hình của Bếp Nàng
Cò là sản xuất “suất ăn công nghiệp” khi số lượng phục vụ ra là hàng chục nghìn suất ăn mỗi ngày. Tuy nhiên, chúng tôi không bao giờ quên nỗi niềm ban đầu khi khởi ý thành lập Bếp Nàng Cò, đó là mang đến cho các con bữa ăn thật ngon miệng, ngon mắt, đầy đủ dinh dưỡng. Để làm được điều đó, Bếp Nàng Cò phải thật sự là căn bếp của tình yêu thương, hàng nghìn hay trăm nghìn suất ăn cũng phải được đầu tư chăm chút như một bữa ăn của chính cha mẹ chuẩn bị cho các con tại nhà.
18
Chúng tôi đã xây dựng những quy trình vận hành tiêu chuẩn, hiệu quả và chất lượng; trang bị cơ sở vật chất với các thiết bị bảo đảm an toàn vệ sinh thực phẩm cho các suất ăn theo tiêu chuẩn quốc tế HACCP (Hazard Analysis and Critical Control Points). Việc bố trí mặt bằng của nhà máy được tách biệt giữa các khâu sản xuất khác nhau như: khu tiếp nhận nguyên liệu, khu rửa nguyên liệu, khu sơ chế, đóng gói và bảo quản. Giữa các khu vực khác nhau luôn có sự kiểm soát chặt chẽ trong di chuyển của nhân viên từ bộ phần này sang bộ phận khác. Tất cả mọi người đều phải đảm bảo yêu cầu về vệ sinh cá nhân trước khi vào phân xưởng sản xuất.


19
Thực đơn Bếp Nàng Cò được thiết kế phù hợp với nhu cầu dinh dưỡng của từng độ tuổi. Các món ăn từ truyền thống đến hiện đại với định lượng, công thức và quy trình chế biến nghiêm ngặt nhằm hướng đến tiêu chí:
- Ngon miệng khi thưởng thức
- Hấp dẫn trong trình bày
- Vui vẽ, mạnh khỏe khi hấp thu


20

21

PHẦN 2: TÌNH CẢM TRONG TRỪNG MÓN ĂN

Ở Bếp Nàng Cò, chúng tôi tin bữa ăn dù có được chế biến từ nguyên liệu đắt tiền, khó kiếm đến mấy cũng không bổ dưỡng bằng việc khi người đứng bếp đặt trọn vẹn tình yêu thương vào món ăn, chăm chút, tỉ mỉ trong từng công đoạn với mong ước các con ăn khỏe, ăn ngon.
22


23

24

Bếp Nàng Cò “
Trao hương vị yêu thương
25
Không bó mình vào những khuôn mẫu sẵn có hay chỉ đánh bóng
thương hiệu bên ngoài, chúng tôi tập trung vào chất lượng cốt lõi, từ đó làm nên những điểm rất riêng cho Bếp Nàng Cò
VARIETY

Món ăn đa dạng, mới
mẻ với sự kết hợp ẩm
thực Á - Âu
Cam kết nguyên liệu
đầu vào từ những nhà cung cấp uy tín
Cân bằng dinh dưỡng, cân bằng âm dương
trong thành phần
nguyên liệu, hạn chế
bột ngọt và giảm vị
mặn đảm bảo phù hợp
với khẩu vị trẻ em
Trung thực trong lời nói và hành động
REPUTATION 26
NUTRITIOUS QUALITY
Để ra được thành phẩm đúng với mong muốn, Bếp Nàng Cò đã xây dựng những tiêu chuẩn đầu vào đặc biệt gắt gao. Việc lựa chọn sản phẩm, nguyên phụ liệu luôn tuân thủ đúng quy định của cơ quan chức năng.
• Nguồn gốc xuất xứ rõ ràng
• Chứng từ kiểm tra, kiểm dịch đầy đủ và còn giá trị sử dụng
• Bảo đảm tiêu chuẩn vận chuyển, đóng gói theo thỏa thuận
• Phụ liệu gia vị không được tồn kho quá 01 tháng
• Thực phẩm chế biến tươi sống không được phép tồn kho, trữ lạnh


27
LƯU MẪU






Dụng cụ lưu mẫu phải có nắp kín: 100g với thức ăn khô và 150ml với thức ăn lỏng.
Dụng cụ lấy mẫu, lưu mẫu thức ăn phải được rửa sạch và tiệt trùng trước khi sử dụng.
Nhiệt độ bảo quản thức ăn ở 2ºC đến 8ºC.
Thời gian lưu mẫu tối thiểu 24 giờ kể từ khi lấy mẫu thức ăn. Khi có người nghi ngờ bị ngộ độc hoặc có yêu cầu của cơ quan quản lý thì không được hủy mẫu lưu cho đến khi có thông báo khác.
Lượng mẫu thức ăn:
•Thức ăn đặc (các món xào, hấp, rán, luộc...), rau, quả ăn ngay: tối thiểu 100 gam
•Thức ăn lỏng (các món súp, canh…): tối thiểu 150ml

Các thông tin về mẫu lưu thức ăn được ghi trên nhãn và cố định vào dụng cụ lưu mẫu thức ăn.
TRÌNH
QUY
1 2 3 4 5 6 28


29



30
•Công cụ, dụng cụ ăn được tráng rửa bằng nước sôi thanh trùng qua máy rửa chén 180ºC. Bộ phận quản lý tiến hành kiểm tra, để ráo và lau khô.
•Các dụng cụ sản xuất và bề mặt tiếp xúc với sản phẩm làm bằng vật liệu không rỉ (Bằng nhựa hoặc bằng inox), không thấm nước, dễ vệ sinh và khử trùng.
•Có đầy đủ các phương tiện rửa và khử trùng tay tại các vị trí thích hợp, luôn trong tình trạng hoạt động tốt.
•Có kế hoạch bảo trì thường xuyên các thiết bị rửa và khử trùng tay cũng như các thiết bị vệ sinh khác.


31
SẠCH
Các bước thực hiện rửa và khử trùng tay trước khi vào xưởng sản xuất.







Rửa nước sạch
Rửa xà phòng, dùng xà phòng rửa kỹ mặt trong và mặt ngoài từng ngón tay và kẽ ngón tay đến tận cổ tay
Rửa lại tay bằng nước sạch cho sạch xà phòng
Nhúng ngập hai tay vào dung dịch Chlorine có nồng độ 10 ppm
Rửa lại tay bằng nước sạch cho sạch Chlorine
Lau khô tay bằng khăn sạch
Xịt cồn đều hai bàn tay
B2
B4
32
SẠCH SẠCH B1
B3
B5 B6

BẢO QUẢN THỰC PHẨM ĐÚNG CÁCH
• Không được bảo quản thực phẩm chín trong tủ lạnh quá 4 ngày, vì một số sinh vật gây ngộ độc có thể phát triển chậm ở nhiệt độ lạnh. Nếu muốn bảo quản thực phẩm chín lâu hơn 4 ngày thì phải làm lạnh đông.
• Có thể giữ thực phẩm luôn nóng bằng cách dùng hơi nóng hoặc đun sôi đều trên bếp trên 600ºC, lúc này các vi khuẩn gây ngộ độc sẽ không thể phát triển được.
• Nếu thực phẩm chín để trên 2 giờ, không thể bảo quản nóng, lạnh hay lạnh đông, thì thực phẩm này không nên ăn ngay mà phải hâm kỹ lại trước khi ăn. Vì sau 4 giờ, số lượng vi khuẩn gây ngộ độc có thể phát triển tới mức độ nguy hiểm.
• Không ăn hoặc sử dụng lại các thức ăn nghi ngờ ôi thiu, mốc, hỏng vì khi có dấu hiệu ôi/ hỏng tức là bản thân thức ăn đã chứa bên trong các chất độc do bị phân hủy, lên men, bị nhiễm vi khuẩn gây bệnh hay độc tố của vi khuẩn, nấm mốc... rất dễ bị ngộ độc, nguy hiểm đến sức khỏe người sử dụng.
33
BẾP NÀNG CÒ



34
HÌNH ẢNH CHỨNG CHỈ AN TOÀN VỆ SINH THỰC PHẦM CỦA





35


PHẦN 3: NIỀM VUI TRÊN BÀN ĂN
36

“
Trẻ con được người lớn nuôi dạy, nhưng có những điều giản đơn đôi khi người lớn phải học từ chính những đứa trẻ. Một trong số đó là cách tận hưởng niềm vui. Thế nên từ ngày đầu thành lập, phương châm mà Bếp Nàng Cò luôn đeo đuổi trong việc chế biến bữa ăn cho trẻ đâu chỉ là ngon, bổ dưỡng mà còn là sự vui thích.
37

38

NIỀM VUI LAN TỎA ĐONG ĐẦY VỊ THƯƠNG “
39

Đối với người làm bếp, còn niềm vui nào hơn khi được thấy “thực
khách” không chỉ ăn ngon miệng mà còn thích thú với món ăn
mình làm ra. Khi các con ăn ngon và hào hứng đến giờ ăn, lúc ấy chúng tôi biết Bếp Nàng Cò đã
đi đúng đường, thực hiện đúng sứ mệnh mình đặt ra ban đầu.
Niềm vui ấy lan tỏa và trở thành động lực cho tất cả nhân viên của Bếp Nàng Cò. Vì chúng tôi tin công việc mình làm mỗi ngày đang góp phần mang đến giá trị cho xã hội, cho cộng đồng không chỉ ở hiện tại mà còn là cho mai sau.

40
HÔM NAY ĂN GÌ?


41
Hôm nay ăn gì?


42

43
Hôm nay ăn gì?




44




45
LỜI CẢM
Nếu sứ mệnh của Bếp Nàng Cò là chung tay thương, thì chính bản thân Bếp Nàng Cò cũng
dưỡng ấy. Theo thời gian, Bếp Nàng Cò ban hình và không ngừng phát triển dưới bàn Bếp Nàng Cò và cả sự góp sức
Chúng tôi chân thành gửi lời cảm ơn đến từng
lực để Bếp Nàng Cò vượt qua những thách thức
đã định. Chúng tôi hy vọng câu chuyện của Bếp nhân, tổ chức có cùng chung mong muốn tốt đẹp nhất qua
Đến đây, cảm ơn Người Bạn của chúng tôi vì đã
cùng và “lắng nghe” câu chuyện của Bếp Nàng bình an và ngày ngày như một đóa Tập thể Bếp


46
CẢM ƠN
nuôi dưỡng mầm non tương lai bằng sự yêu cũng đang lớn lên từng ngày bởi nguồn dinh
đầu từ một hạt mầm ý tưởng nay đã thành bàn tay chăm sóc, thương yêu của đội ngũ sức của Khách hàng, Đối tác.
cá nhân, tập thể đã – đang góp một phần sức thức và tiếp tục vững bước trên con đường mình
Bếp Nàng Cò sẽ còn được viết tiếp bởi những cá mang đến cho thế hệ mai sau những điều qua mỗi bữa ăn.
đã dành thời gian lật mở đến những trang cuối Nàng Cò. Thương chúc tất cả luôn khỏe mạnh, đóa hoa, luôn góp hương sắc cho đời.
Bếp Nàng Cò


47
Chúng tôi luôn sẵn sàng chào đón những người bạn đồng hành cùng chung chí hướng, đồng lòng viết tiếp những chương mới cho Bếp Nàng Cò. Dưới đây là thông tin liên hệ của chúng tôi.

Hotline:…….Email:……..Địachỉ:…….
48